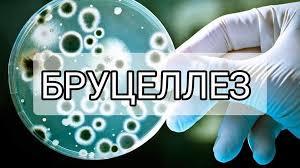

Бруцеллез – медицина саласында малдан адамға жұғатын жұқпалы ауру. Бруцеллез қазақша Сарып ауру деп аталады. Эпидемиологиясы бойынша барлық жерде кең тараған ауру. Инфекция көзі ұсақ мүйізді, ірі қара мал, шошқа және адамдар болып табылады.
Бруцеллез ауруы малдан адамға жұғатын ауру. Аурудың қоздырғышы бруцелл - суыққа төзімді, ыстыққа төзімсіз бактерия. Бруцеллез - сүтті қайнатқанда және пастерлегенде бірден жойылады, заттарды дезинфекциялағанда бірнеше минуттан 3-4 сағат аралығында өледі, топырақта 3 ай, суда және тоңазытылған етте 5 айдай, сиыр сүтінде 45 күн, тұздалған қой терілерінде 2 ай, мал жүнінде 4 айдан артық тіршілігін сақтай алады. Таралу жолдары қоздырғышпен ластанған жем, су, көң, тезек арқылы жұғады, ал адамдар ауру малды күтіп-ұстауда, әсіресе жарақаты бар қолдармен мал төлдету кезінде, мал сою және бөлшектеу кезінде, мал өнімдері мен шикізатымен айналысқан кезде, тағамға ауру малдың сүтін қайнатпай ішуден, сүт, ет өнімдерін пайдалану кезінде, ауру малдың жүнін өңдегенле, тезек жинағанда, мал қораларын қөңнен тазалау кезінде ұшқан шаң тозаң арқылы жұғуы мүмкін. Ауырған адамның дене қызуы көтеріліп, қалтырап, әлсіздік пайда болады, асқа тәбеті болмайды, жүйке, жүрек, қан тамырлары жүйесі, әсіресе буындары зақымдануы мүмкін. Науқасты қалың тер басып, басы ауырып, буыны мен бұлшық еттері сырқырайды. Ыстықтың көтерілуі жеңіл және ауыр формада өтуі мүмкін. Түстен кейін қалтырап тоңса, ертеңгі күні малшынып терлеуі мүмкін. Созылмалы бруцеллезде ыстық бірненше күн басылып, қайта көтеріледі. Мойында, қолтықтың астында, шапта ісінген лимфа түйінділер пайда болуы мүмкін. Ауруды дұрыс емдемесе еңбекке жарамсыздыққа әкеледі. Ауру белгілері пайда болса, тез арада дәрігерге көрініп, ем қабылдау қажет.
Аурудың алдын алудың маңызды жолы жеке бас гигиенасын сақтау. Алдын алу шаралары бойынша малмен және оның өнімдерімен жұмыс барысында арнайы киіммен, қолғаппен жұмыс жасау қажет. Балаларды бруцеллезбен ауыратын малдарды күтуге және оларды ұстайтын малқораға кіргізбеу. Қол жарақаты болса мұқият таңу, жұмыстан кейін қолды мұқият жуу, жұмыс киімін ауыстыру, ет, сүт өнімдерін тексеруден өткен анықтамасы бар арнайы сауда - саттық орындардан алу, ет пен сүт өнімдерін тек қайнатып, пісірілген соң пайдалану, мал базарынан малдарды анықтамасымен алу, үй жануарларын ветеринарға тексерту, ауру мал анықталған жағдайда оқшаулау, мал орындарын тазарту, залалсыздандыру болып табылады.
Б.Абилова, бас маман